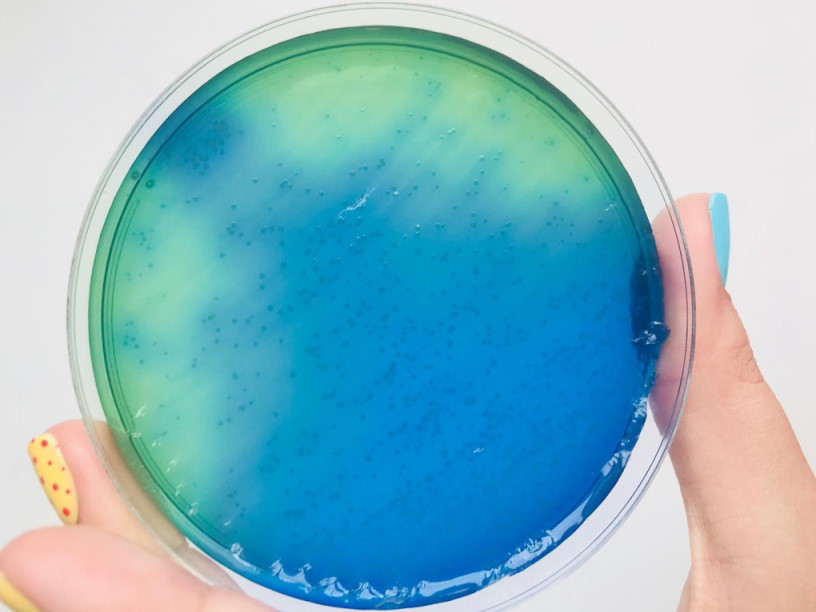

Промикробы: Кто проживает на дне океана
Я в долгожданном отпуске, поэтому думать и говорить могу только о море. Так что нравится вам это или нет, сегодня будем знакомиться с удивительным миром морских бактерий. В море можно встретить как уже хорошо вам знакомую кишечную палочку, так и абсолютно уникальные микроорганизмы, которые больше нигде не встречаются.
⠀
Бактерии северных морей, естественно, имеют совершенно иной температурный оптимум, чем привычные нам патогены. Логично, что малышам, привыкшим жить в теле человека, подавай 37 градусов, а отважным северным микропиратам достаточно 10 градусов. Конечно, жизнь в таких условиях потребовала определенных перестроек метаболизма. Кроме холода, в море совершенно иное осмотическое давление, чем в нашем организме или на колбасе, которая давно лежит в холодильнике. Большинство бактерий живут в средах, имеющих концентрацию солей до 1 %. Морские же бактерии требуют для своего развития концентрацию солей до 10 %. В озере Гюсчун-даг в Закавказье живут бактерии, приспособившиеся к концентрации солей 36 %! Эта группа микробов, живущая в водах с высокой концентрацией солей, называется галофилами.
⠀
Одни любят соль, а другим подавай побольше серы. Серобактерии, они же тиобактерии, — весьма разнородная группа прокариотов, окисляющих восстановленные соединения серы. Обитают в пресных и соленых водах. Энергию для синтеза органических веществ они получают, окисляя сероводород или другие восстановленные соединения серы: сульфиды металлов, полисульфиды, неорганические тиосульфаты, политионаты, молекулярную серу. Колоссальное количество серных бактерий имеется в Черном море, где на глубине около 200 м вода насыщена сероводородом. Предполагают, что он поступает в море из земных глубин через разломы донных пород.
⠀
Серные бактерии, образуя серную кислоту, способствуют разрушению горных пород, каменных и металлических сооружений. Известны случаи коррозии бетонных конструкций (например, канализационных труб) с участием этих бактерий — бетон содержит серу, которую серобактерии окисляют до сульфата, что повышает концентрацию протонов в растворе у поверхности труб, а это, в свою очередь, ведет к растворению карбонатов, входящих в состав бетона, и к интенсивному разрушению труб. Илы, содержащие серобактерии, применяют для очистки сточных вод от сероводорода, а также для выщелачивания сульфидных руд.
⠀
Самым удивительным местом для жизни в океане являются так называемые «черные курильщики», их полное название — гидротермальные источники срединно-океанических хребтов. Из них в океаны поступает высокоминерализованная горячая вода под давлением в сотни атмосфер. Они представляют собой трубообразные образования, достигающие высоты в десятки метров. Только представьте — самое дно океана, темнота, холод, среди всего этого под жутким напором бьет раскаленная минералка. И бактерии такие: «Идеально, тут мы и поселимся». «Курильщики» извергают геотермальную воду температурой до 400 °C. Из-за большого давления эта вода не кипит, а находится в сверхкритическом состоянии. Причина черного цвета и мутности — взвесь сульфидов металлов.
⠀
Несложно догадаться, что на фотосинтезе в таких условиях не протянуть, поэтому бактерии занимаются хемосинтезом, используя то, что дает «курильщик». Созданная этими хемосинтезирующими бактериями экосистема является самой глубокой частью биосферы, достигает глубины 2500 метров и более. Некоторые исследования утверждают, что последний общий предок всех живых организмов мог быть жителем именно гидротермального источника, примерно 3,8 млрд лет назад. В каком-то смысле все мы вышли не из «Шинели» Гоголя, а из «черных курильщиков».